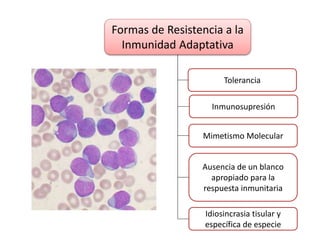
Formas de Resistencia a la
Inmunidad Adaptativa
Inmunosupresión
Mimetismo Molecular
Tolerancia
Ausencia de un blanco
apropiado para la
respuesta inmunitaria
Idiosincrasia tisular y
específica de especie

El documento presenta una introducción a la interacción entre hospedador, agente y ambiente en las enfermedades. Explica que factores ambientales como la nutrición, el estrés y la temperatura pueden afectar la susceptibilidad del hospedador, al igual que factores relacionados con el agente causal como las toxinas y la evasión del sistema inmune. También describe mecanismos del hospedador para resistir la infección como la inmunidad innata y adaptativa.